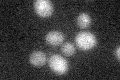
YPR201W
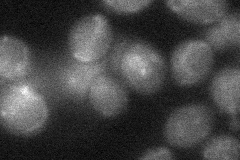
YPR201W

View description
Arsenite transporter of the plasma membrane, required for resistance to arsenic compounds; transcription is activated by Arr1p in the presence of arsenite
Localization:
Intensity:
Fold change:
Significance:
-
C’ GFP library in SD
below threshold15.87 -
N' NOP1pr-GFP in SD

punctate,vacuole66.182 -
N' TEF2pr-mCherry in SD

ER,vacuole121.952 -
N' NATIVEpr-GFP in SD

below threshold20.0879 -
N' TEF2pr-VC and Cyto-VN in SD
below threshold26.2199 -
C’ GFP library in SD+DTT

cytosol15.430.97No -
C’ GFP library in SD+H2O2

cytosol13.820.87No -
C’ GFP library in Starvation Media

cytosol17.51.1No -
C’ GFP library on the background of Pup2-DaMP

below threshold -
C’ GFP library on the background of CCT mutant

below threshold13.17990.829931No
